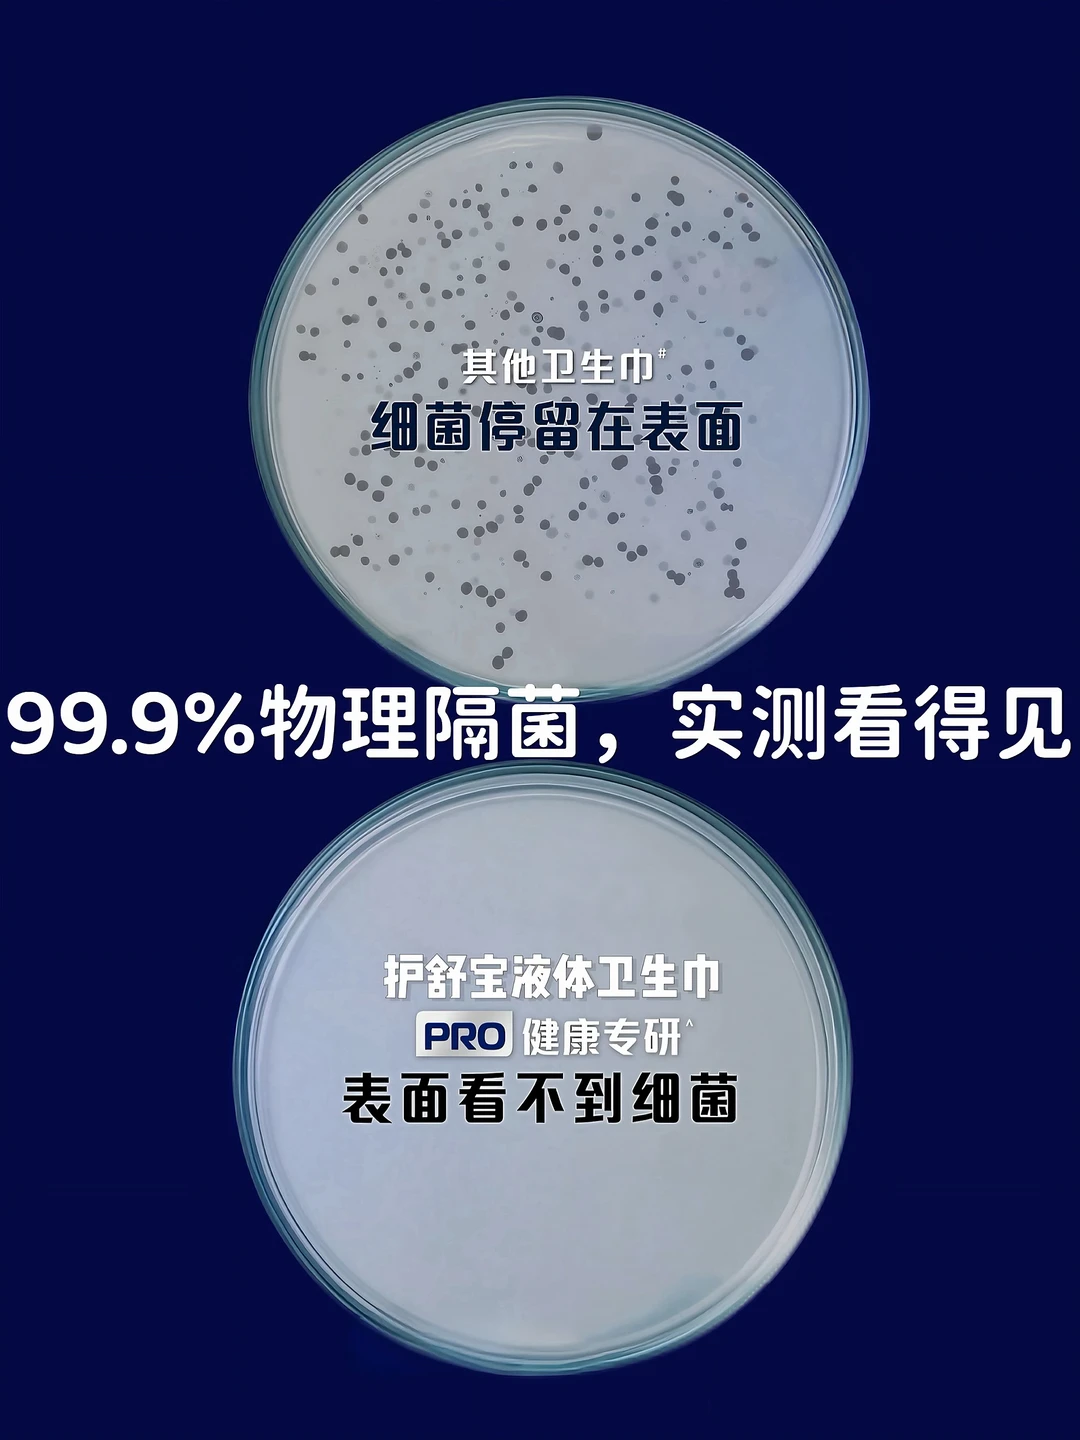

天冷后身体总感觉沉沉的,这时候既要增强抵抗力,更要吃得舒服养人~~
特别在经期,吃一顿热乎乎的饭菜,暖身又暖心,舒服到骨子里!
.
我今天吃的是被央妈点名推荐的冬季食谱:
西红柿炖牛腩+荷兰豆炒肉末+玉米杂粮饭
干净健康,却又不失滋味!
肠胃和身心都超满足[萌萌哒R]
关键还特别好上手!做起来也简单~
.
🍅 所需食材:番茄、土豆、牛腩、荷兰豆、猪肉、葱姜蒜、小米辣/八角/香叶
具体做法在P3&P11哦~期待各位的分享!!
.
一顿热乎乎的饭菜下肚也太舒服了~
经期身体真的超敏感!尤其是在冬天,早晚温差大,抵抗力也跟着下降[完啦R]
各种不舒服找上门...私处就很容易感觉闷闷痒痒的,真的太糟心了[哭惹R]
后来还专门去了医院,医生说如果总是闷痒不适,可能是卫生巾没选好,卫生巾无法做到真正隔菌,让经血长期接触皮肤,再加上经期抵抗力变低,细菌就很容易趁虚而入!
这时我才意识到,经期不止要内调,外护的卫生巾也很重要!就听劝入手了全新上市的护舒宝物理隔菌卫生巾,一试就立马被圈粉,彻底爱上~
还想给闺蜜安利呢,没想到她用的一直是这个!
她说当时就是研究了一番,发现只有护舒宝的这个物理隔菌卫生巾有独创的物理隔菌技术❗️
双层隔离,上层隔湿下层锁菌,可以做将99.9%的血和细菌都直接吸到底下(👈有国家级实验室实测认证哦~,那些黏糊的液体不会和肌肤接触!所以才选择了这个~
后来有次在外面玩很久回家,发现卫生巾表面真的依旧干爽,完全没有闷湿痒的情况!
真的不愧是被央妈和多位女性健康专家权威认证过的卫生巾呀!
而且不止隔菌,还特别柔软,像小宝宝的衣服一样,完全不会磨大腿~~真的舒适又安心!!
姐妹们,再忙也别亏待自己,好好吃饭,经期更要好好爱自己✨